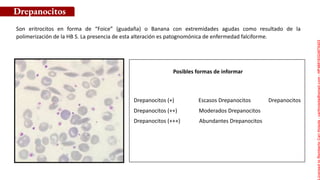
Posibles formas de informar
Son eritrocitos en forma de “Foice” (guadaña) o Banana con extremidades agudas como resultado de la
polimerización de la HB S. La presencia de esta alteración es patognomónica de enfermedad falciforme.
Drepanocitos
Drepanocitos (+) Escasos Drepanocitos Drepanocitos
Drepanocitos (++) Moderados Drepanocitos
Drepanocitos (+++) Abundantes Drepanocitos
Licensed
to
Remberto
Cari
Hojeda
-
carihojeda@gmail.com
-
HP46816324875423
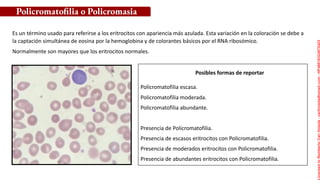
Posibles formas de reportar
Es un término usado para referirse a los eritrocitos con apariencia más azulada. Esta variación en la coloración se debe a
la captación simultánea de eosina por la hemoglobina y de colorantes básicos por el RNA ribosómico.
Normalmente son mayores que los eritrocitos normales.
Policromatofilia o Policromasia
Policromatofilia escasa.
Policromatofilia moderada.
Policromatofilia abundante.
Presencia de Policromatofilia.
Presencia de escasos eritrocitos con Policromatofilia.
Presencia de moderados eritrocitos con Policromatofilia.
Presencia de abundantes eritrocitos con Policromatofilia.
Licensed
to
Remberto
Cari
Hojeda
-
carihojeda@gmail.com
-
HP46816324875423
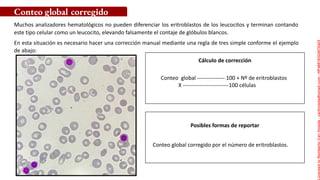
Posibles formas de reportar
Conteo global corregido por el número de eritroblastos.
Muchos analizadores hematológicos no pueden diferenciar los eritroblastos de los leucocitos y terminan contando
este tipo celular como un leucocito, elevando falsamente el contaje de glóbulos blancos.
En esta situación es necesario hacer una corrección manual mediante una regla de tres simple conforme el ejemplo
de abajo:
Cálculo de corrección
Conteo global --------------- 100 + Nº de eritroblastos
X -------------------------100 células
jjnjnmn
Conteo global corregido
Licensed
to
Remberto
Cari
Hojeda
-
carihojeda@gmail.com
-
HP46816324875423

El documento presenta un resumen de las observaciones microscópicas más comunes realizadas en un hemograma, incluyendo términos como anisocitosis, microcitosis, macrocitosis, hipocromía y diferentes formas anormales de eritrocitos como ovalocitos, dacriocitos y esquistocitos. Explica cada término con detalle y ofrece posibles formas de informar los hallazgos de manera cualitativa y semiquantitativa. Los autores son profesionales de la salud especializados en hematología con experiencia

![Posibles formas de informar
Determinación diferencial no realizada debido a baja
celularidad. Resultado liberado por automatización. En el
análisis de la lámina (frotis) fueron observadas células
[inmaduras, células blásticas o displásicas, por ejemplo] .
Presencia de células [inmaduras, células blásticas o displásicas,
por ejemplo] en la muestra analizada.
Muchas veces debido a una leucopenia intensa, el contaje diferencial queda perjudicado, no siendo posible realizar el
conteo de 100 células.
En estos casos, aunque la cuenta diferencial no sea realizada, es importante que la lámina sea examinada para ver si
existen o no presencia de granulocitos inmaduros, células blásticas o displásicas, porque deben de ser reportadas al
estar presentes.
Intensa leucopenia
Licensed
to
Remberto
Cari
Hojeda
-
carihojeda@gmail.com
-
HP46816324875423](https://image.slidesharecdn.com/ebookobservacionesdelhemograma-210924135335/85/Ebook-observaciones-del-hemograma-pptx-52-320.jpg)












